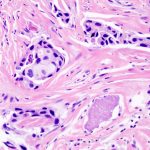
Oncologie : Waiv obtient le marquage CE-IVDR de deux tests de précision

Cancer du pancréas : découverte d’une nouvelle famille de cellules immunitaires chez les « super-répondeurs »
Cancer du pancréas : découverte d’une nouvelle famille de cellules immunitaires chez les «...
27 avril 2026
Cancer du pancréas : découverte d’une nouvelle famille de cellules immunitaires chez les «...

1 avril 2026




27 janvier 2026




9 septembre 2025









